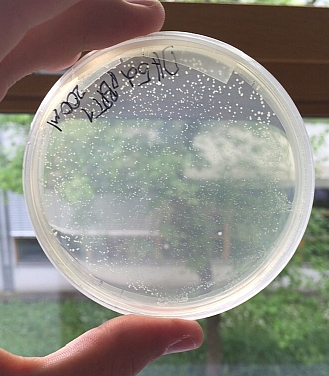

Team BioProzessTechnik (Fermenterlabor)

Foto: Laaser - 12/16
Vortrag (David Bittner) und Posterpräsentation
ProcessNet-Jahrestagung und 32. DECHEMA-Jahrestagung der Biotechnologen
2016
12. - 15. September 2016 Eurogress Aachen
 
Vortrag (David Bittner) auf der TMFB-Tagung
Exzellenzcluster Tailor-Made Fuels from Biomass (TMFB)
21. - 23. Juni 2016 Eurogress/Aachen

Poster auf der DECHEMA-Tagung "New Frontiers for
Biotech-Processes"
2. - 4. Mai 2016 Rhein-Mosel-Halle Koblenz/Germany

--- BioProcessingDays
2016
22. - 24.02.2016
an der Westfälischen Hochschule / Standort: Recklinghausen

 
Links: Dr. Holger Müller, Prof. Frank Eiden, Prof.
Michael Brodmann --- Rechts: Christoph Halbfeld (RWTH Aachen) -
Posterpreisgewinner

Sponsoren
LINK

Poster auf der 3. intern. TMFB-Konferenz (23.-25.06.15) - Tailor-Made
Fuels from Biomass- Aachen

Poster auf Dechema-Tagung (11.-13.05.15) - Scale-up and scale-down of
bioprocesses - Hamburg

synthetisches Plasmid BPT1 eingetroffen (07.05.15)
(Fermentation mit E.coli
BW25113 pLB4 in Parallel-Glasfermentern)

-
21.-22.11.14: Projekt KICK-OFF
in
Kevelaer-Kervendonk
(Rouenhof)
-
02.10.14: Arbeitsgruppe BioProzessTechnik erhält Bewilligung für das
Projekt
"Process-Factory (ProFact)
Integrative Methode zur beschleunigten Entwicklung von
Bio-Produktionsverfahren am Beispiel der nachhaltigen Herstellung einer
Industriechemikalie"
vom BMBF über 3 Jahre
Partner: RWTH
Aachen, BlueSens gassensor GmbH, engineo GmbH, ARTES Biotechnology GmbH

 

Jahrestagung der Biotechnologen, Aachen - 01.10.14
 David
Bittner / Frank Eiden - Dechema Jahrestagung der Biotechnologen
(Aachen) - 01.10.14 / Posterpräsenstation (gem. mit der BlueSens
gas sensor GmbH)
Biotechnica - Hannover
Stand bei der BlueSens gas sensor GmbH
http://www.youtube.com/watch?v=9GlkrYbGiVU

2. Platz (Poster) - BioTrends-2012
(Frank Eiden, Christina Stracke, Lars Blank
(RWTH), David Bittner)

zum Poster

Neue Analytik: Shimadzu HPLC
 |